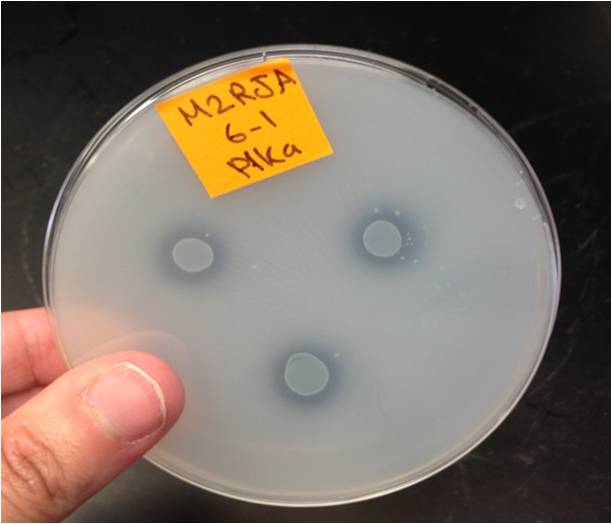

About This Project
Bacteria (endophytes) have the talent to get inside green plants aid the plant in fostering nutrient acquisition.These bacteria have potential to replace synthetic commercial fertilizers and pesticides as plant growth aids.We have isolated 33endophytic bacterial strains and want to examine their ability to produce specific hormones benefiting plant growth.We will also determine if the endophytes enhance plant seedling,root growth and development.
Ask the Scientists
Join The DiscussionWhat is the context of this research?
Bacteria that can be isolated from the interior of plants
(endophytes) are deserving of more study and potential use in agriculture, because their beneficial effects on plant growth could help replace commercial fertilizers and pesticides. Some of the benefits plants can obtain from associating with endophytes include improved nutrient acquisition via bacterial nitrogen fixation and phosphate solubilization, pathogen control via bacterial antibiotic production, and triggering by the bacteria of plant defense pathways to protect against plant pathogens. Also, some endophytes produce plant hormones (including gibberllic acid, auxins, and cytokinins) and enzymes that promote plant growth and health.
What is the significance of this project?
With increasing awareness towards the value of organic
farming,concerns about commercial pesticide using,and current agricultural practices depleting soil nutrients, new approaches are needed to aid growth and health of agricultural plants.Technological development of selected endophytic bacterial strains that can promote plant growth could be one of these new approaches. Endophytes face less stress, being secure and sheltered inside their host plant. Isolation of beneficial endophytes could lead to their development as commercial products to help minimize or eliminate commercial fertilizers and practices depleting organic and inorganic soil nutrients. Also, the ability of some endophytes to protect against plant pathogens could help minimize use of commercial pesticides.
What are the goals of the project?
- Examination of the isolated bacterial strains for in-vitro
plant growth promoting (PGPR) activities by extracting and quantifying gibberellic acid, auxins, cytokinins and the enzyme aminocylcopropane carboxylase (ACC) that acts as a plant growth promoting enzyme. - Based on results from (1), endophyte strains that appear most promising in PGPR activities would be analyzed for the ability to enhance root growth and development using radish seedling and Arabidopsis bioassays.
- The selected bacterial strains would be analyzed for biological control against selected plant pathogens, such as the fungus
Budget
In order to obtain the necessary data, we need to purchase
different microbial culture media, inorganic chemicals, and organic solvents for plant hormone extraction and analysis, and to have funds to pay for contractual use of equipment in a common use university core facility. Budget will also pay for materials needed to do plant seedling bioassays for the effect of endophytes on seedling root development ; and bioassays for the ability of endophyte strains to antagonize or inhibit growth of plant pathogenic microbes including the fungus Fusarium graminearium.
Meet the Team
Team Bio
I am a Master student in Microbiology department at SouthDakota State University. My current focus is plants microbiology , and I am currently in the lab of Dr. Bruce Bleakley. I have always been interested in study the interaction of microorganism with another organisms ,and their impact activities on the environment; and most importantly to help in saving the vanishing species due to global environmental stress. My current research focuses on studying different strains of endophytic bacteria which were isolated from Hot springs in South Dakota, and Investigating their effects on plants, using different assays to analyze plant growth hormones produced by these bacteria which are needed to aid growth and health of agricultural plants in the world.
Mada Ashkan
I am a Master student in Microbiology department at South
Dakota State University. My current focus is plants microbiology , and I am currently in the lab of Dr. Bruce Bleakley. I have always been interested in study the interaction of microorganism with another organisms and their impact activities on the environment; and most importantly to help in saving the vanishing species due to global environmental stress. My current research focuses on studying different strains of endophytic bacteria which were isolated from Hot springs in South Dakota, and Investigating their effects on plants, using different assays to analyze plant growth hormones produced by these bacteria.
Lab Notes
Nothing posted yet.
Additional Information
Role of endophtic bacteria in plant growth
Indole Acetic Acid (IAA) extracted from M1RNA 11-1 bacteria
phosphate solublization experiment which shows a positive result (M2RJA 6-1 ) bacteria grew and formed a halo zone around the growth on Pikovskaya medium having a tricalcium phosphate(Ca3 (PO4)2), as a source of insoluble phosphate.
Project Backers
- 7Backers
- 3%Funded
- $93Total Donations
- $13.29Average Donation
